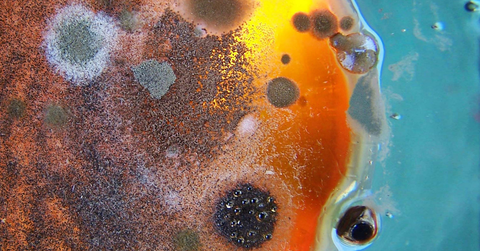
Mold/Mycotoxins

Evaluation of oxidative stress in colorectal cancer patients
Chang D, Wang F, Zhao YS, Pan HZ. Evaluation of oxidative stress in colorectal cancer patients.PMID: 18837290
The significant changes in antioxidant enzyme activity after GSH depletion suggest that thiol status can influence the regulation of other antioxidant enzymes
Morrison JP, Coleman MC, Aunan ES, Walsh SA, Spitz DR, Kregel KC. The significant changes in antioxidant enzyme activity after GSH depletion suggest that thiol status can influence the regulation of other antioxidant enzymes. Biomed Environ Sci. 2008 Aug;21(4):286-9. PMID: 15947071
Age-related changes in the glutathione redox system
Erden-Inal M, Sunal E, Kanbak G. Age-related changes in the glutathione redox system. Cell Biochem Funct. 2002 Mar;20(1):61-6. PMID: 11835271
High blood glutathione levels accompany excellent physical and mental health in women ages 60 to 103 years
Lang CA, Mills BJ, Lang HL, Liu MC, Usui WM, Richie J Jr, Mastropaolo W, Murrell SA. High blood glutathione levels accompany excellent physical and mental health in women ages 60 to 103 years. J Lab Clin Med. 2002 Dec;140(6):413-7. PMID: 12486409
Increased oxidative stress with aging reduces chondrocyte survival: correlation with intracellular glutathione levels
Carlo MD Jr, Loeser RF. Increased oxidative stress with aging reduces chondrocyte survival: correlation with intracellular glutathione levels. Arthritis Rheum. 2003 Dec;48(12):3419-30. PMID: 14673993
GSH and analogs in antiviral therapy
Fraternale A, Paoletti MF, Casabianca A, Nencioni L, Garaci E, Palamara AT, Magnani M. GSH and analogs in antiviral therapy. Mol Aspects Med. 2009 Feb-Apr;30(1-2):99-110. Epub 2008 Sep 27. PMID: 18926849
Glutathione: a vital lens antioxidant
Giblin FJ. Glutathione: a vital lens antioxidant. J Ocul Pharmacol Ther. 2000 Apr;16(2):121-35. PMID: 10803423